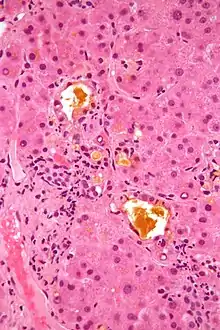

Bile (from Latin bilis), or gall, is a yellow-green fluid produced by the liver of most vertebrates that aids the digestion of lipids in the small intestine. In humans, bile is primarily composed of water, produced continuously by the liver, and stored and concentrated in the gallbladder. After a human eats, this stored bile is discharged into the first section of their small intestine.[1]
Composition
In the human liver, bile is composed of 97–98% water, 0.7% bile salts, 0.2% bilirubin, 0.51% fats (cholesterol, fatty acids, and lecithin), and 200 meq/L inorganic salts.[2][3] The two main pigments of bile are bilirubin, which is yellow, and its oxidised form biliverdin, which is green. When mixed, they are responsible for the brown color of feces.[4] About 400 to 800 milliliters (14 to 27 U.S. fluid ounces) of bile is produced per day in adult human beings.[5]
Function


Bile or gall acts to some extent as a surfactant, helping to emulsify the lipids in food. Bile salt anions are hydrophilic on one side and hydrophobic on the other side; consequently, they tend to aggregate around droplets of lipids (triglycerides and phospholipids) to form micelles, with the hydrophobic sides towards the fat and hydrophilic sides facing outwards. The hydrophilic sides are negatively charged, and this charge prevents fat droplets coated with bile from re-aggregating into larger fat particles. Ordinarily, the micelles in the duodenum have a diameter around 1–50 μm in humans.[6]
The dispersion of food fat into micelles provides a greatly increased surface area for the action of the enzyme pancreatic lipase, which digests the triglycerides, and is able to reach the fatty core through gaps between the bile salts.[7] A triglyceride is broken down into two fatty acids and a monoglyceride, which are absorbed by the villi on the intestine walls. After being transferred across the intestinal membrane, the fatty acids reform into triglycerides (re-esterified), before being absorbed into the lymphatic system through lacteals. Without bile salts, most of the lipids in food would be excreted in feces, undigested.[8]
Since bile increases the absorption of fats, it is an important part of the absorption of the fat-soluble substances,[9] such as the vitamins A, D, E, and K.[10]
Besides its digestive function, bile serves also as the route of excretion for bilirubin, a byproduct of red blood cells recycled by the liver. Bilirubin derives from hemoglobin by glucuronidation.
Bile tends to be alkaline on average. The pH of common duct bile (7.50 to 8.05) is higher than that of the corresponding gallbladder bile (6.80 to 7.65). Bile in the gallbladder becomes more acidic the longer a person goes without eating, though resting slows this fall in pH.[11] As an alkali, it also has the function of neutralizing excess stomach acid before it enters the duodenum, the first section of the small intestine. Bile salts also act as bactericides, destroying many of the microbes that may be present in the food.[12]
Clinical significance
In the absence of bile, fats become indigestible and are instead excreted in feces, a condition called steatorrhea. Feces lack their characteristic brown color and instead are white or gray, and greasy.[13] Steatorrhea can lead to deficiencies in essential fatty acids and fat-soluble vitamins.[14] In addition, past the small intestine (which is normally responsible for absorbing fat from food) the gastrointestinal tract and gut flora are not adapted to processing fats, leading to problems in the large intestine.[15]
The cholesterol contained in bile will occasionally accrete into lumps in the gallbladder, forming gallstones. Cholesterol gallstones are generally treated through surgical removal of the gallbladder. However, they can sometimes be dissolved by increasing the concentration of certain naturally occurring bile acids, such as chenodeoxycholic acid and ursodeoxycholic acid.[16][17]
On an empty stomach – after repeated vomiting, for example – a person's vomit may be green or dark yellow, and very bitter. The bitter and greenish component may be bile or normal digestive juices originating in the stomach.[18] Bile may be forced into the stomach secondary to a weakened valve (pylorus), the presence of certain drugs including alcohol, or powerful muscular contractions and duodenal spasms. This is known as biliary reflux.[19]
Obstruction
Biliary obstruction refers to a condition when bile ducts which deliver bile from the gallbladder or liver to the duodenum become obstructed. The blockage of bile might cause a buildup of bilirubin in the bloodstream which can result in jaundice. There are several potential causes for biliary obstruction including gallstones, cancer,[20] trauma, choledochal cysts, or other benign causes of bile duct narrowing.[21] The most common cause of bile duct obstruction is when gallstone(s) are dislodged from the gallbladder into the cystic duct or common bile duct resulting in a blockage. A blockage of the gallbladder or cystic duct may cause cholecystitis. If the blockage is beyond the confluence of the pancreatic duct, this may cause gallstone pancreatitis. In some instances of biliary obstruction, the bile may become infected by bacteria resulting in ascending cholangitis.
Society and culture
In medical theories prevalent in the West from classical antiquity to the Middle Ages, the body's health depended on the equilibrium of four "humors", or vital fluids, two of which related to bile: blood, phlegm, "yellow bile" (choler), and "black bile". These "humors" are believed to have their roots in the appearance of a blood sedimentation test made in open air, which exhibits a dark clot at the bottom ("black bile"), a layer of unclotted erythrocytes ("blood"), a layer of white blood cells ("phlegm") and a layer of clear yellow serum ("yellow bile").[22]
Excesses of black bile and yellow bile were thought to produce depression and aggression, respectively, and the Greek names for them gave rise to the English words cholera (from Greek χολή kholē, "bile") and melancholia. In the former of those senses, the same theories explain the derivation of the English word bilious from bile, the meaning of gall in English as "exasperation" or "impudence", and the Latin word cholera, derived from the Greek kholé, which was passed along into some Romance languages as words connoting anger, such as colère (French) and cólera (Spanish).[23]
Soap
Soap can be mixed with bile from mammals, such as ox gall. This mixture, called bile soap[24] or gall soap, can be applied to textiles a few hours before washing as a traditional and effective method for removing various kinds of tough stains.[25]
Food
"Pinapaitan" is a dish in Philippine cuisine that uses bile as flavoring.[26] Other areas where bile is commonly used as a cooking ingredient include Laos and northern parts of Thailand.
Bears
In regions where bile products are a popular ingredient in traditional medicine, the use of bears in bile-farming has been widespread. This practice has been condemned by activists, and some pharmaceutical companies have developed synthetic (non-ursine) alternatives.[27]
Principal acids
See also
References
- ↑ Puestow, Charles B. (1931-12-01). "The Discharge of Bile into the Duodenum". Archives of Surgery. 23 (6): 1013–1029. doi:10.1001/archsurg.1931.01160120127008. ISSN 0272-5533.
- ↑ Barrett, Kim E.; Barman, Susan M.; Boitano, Scott; Brooks, Heddwen L. (2012). Ganong's Review of Medical Physiology (24th ed.). New York: McGraw-Hill Medical. p. 512. ISBN 978-0-07-178003-2.
- ↑ Guyton and Hall (2011). Textbook of Medical Physiology. U.S.: Saunders Elsevier. p. 784. ISBN 978-1-4160-4574-8.
- ↑ "Bile pigments - Oxford Reference". www.oxfordreference.com. Retrieved 2020-01-20.
- ↑ "Secretion of Bile and the Role of Bile Acids In Digestion". www.vivo.colostate.edu. Retrieved 2017-03-31.
- ↑ Dickinson, Eric; Leser, Martin E. (2007-10-31). Food Colloids: Self-Assembly and Material Science. Royal Society of Chemistry. p. 22. ISBN 978-1-84755-769-8.
- ↑ Lowe, Mark E. (2002-12-01). "The triglyceride lipases of the pancreas". Journal of Lipid Research. 43 (12): 2007–2016. doi:10.1194/jlr.R200012-JLR200. ISSN 0022-2275. PMID 12454260.
- ↑ Starr, Cecie (2007-09-20). Biology: Concepts and Applications. Cengage Learning. p. 650. ISBN 978-0-495-11981-4.
- ↑ "Secretion of Bile and the Role of Bile Acids In Digestion". www.vivo.colostate.edu. Retrieved 2016-06-05.
- ↑ "Secretion of Bile and the Role of Bile Acids In Digestion". www.vivo.colostate.edu. Retrieved 2018-04-09.
- ↑ Sutor, D. June (1976). "Diurnal Variations in the pH of Pathological Gallbladder Bile". Gut. 17 (12): 971–974. doi:10.1136/gut.17.12.971. PMC 1411240. PMID 14056.
- ↑ Merritt, M. E.; Donaldson, J. R. (2009-09-17). "Effect of bile salts on the DNA and membrane integrity of enteric bacteria". Journal of Medical Microbiology. 58 (12): 1533–1541. doi:10.1099/jmm.0.014092-0. ISSN 0022-2615. PMID 19762477.
- ↑ Barabote RD, Tamang DG, Abeywardena SN, et al. (2006). "Extra domains in secondary transport carriers and channel proteins". Biochim. Biophys. Acta. 1758 (10): 1557–79. doi:10.1016/j.bbamem.2006.06.018. PMID 16905115.
- ↑ Azer, Samy A.; Sankararaman, Senthilkumar (2019), "Steatorrhea", StatPearls, StatPearls Publishing, PMID 31082099, retrieved 2020-01-20
- ↑ Gorbach, Sherwood L. (1971-06-01). "Intestinal Microflora". Gastroenterology. 60 (6): 1110–1129. doi:10.1016/S0016-5085(71)80039-2. ISSN 0016-5085. PMID 4933894.
- ↑ Bell, G. D. (1980-01-01), Dukes, M. N. G. (ed.), Drugs used in the management of gallstones, Side Effects of Drugs Annual, vol. 4, Elsevier, pp. 258–263, doi:10.1016/S0378-6080(80)80042-0, ISBN 9780444901309, retrieved 2020-01-20
- ↑ Guarino, Michele Pier Luc a; Cocca, Silvia; Altomare, Annamaria; Emerenziani, Sara; Cicala, Michele (2013-08-21). "Ursodeoxycholic acid therapy in gallbladder disease, a story not yet completed". World Journal of Gastroenterology. 19 (31): 5029–5034. doi:10.3748/wjg.v19.i31.5029. ISSN 1007-9327. PMC 3746374. PMID 23964136.
- ↑ Choices, NHS. "Nausea and vomiting in adults - NHS Choices". www.nhs.uk. Retrieved 2016-06-05.
- ↑ Iacobuzio-Donahue, Christine A.; Montgomery, Elizabeth A. (2011-06-06). Gastrointestinal and Liver Pathology E-Book: A Volume in the Series: Foundations in Diagnostic Pathology. Elsevier Health Sciences. p. 71. ISBN 978-1-4557-1193-2.
- ↑ Boulay, Brian R; Birg, Aleksandr (2016-06-15). "Malignant biliary obstruction: From palliation to treatment". World Journal of Gastrointestinal Oncology. 8 (6): 498–508. doi:10.4251/wjgo.v8.i6.498. ISSN 1948-5204. PMC 4909451. PMID 27326319.
- ↑ Shanbhogue, Alampady Krishna Prasad; Tirumani, Sree Harsha; Prasad, Srinivasa R.; Fasih, Najla; McInnes, Matthew (2011-08-01). "Benign Biliary Strictures: A Current Comprehensive Clinical and Imaging Review". American Journal of Roentgenology. 197 (2): W295–W306. doi:10.2214/AJR.10.6002. ISSN 0361-803X. PMID 21785056.
- ↑ Johansson, Ingvar; Lynøe, Niels (2008). Medicine & Philosophy: A Twenty-First Century Introduction. Walter de Gruyter. p. 27. ISBN 9783110321364. Retrieved 2015-04-23.
If blood is poured into a glass jar, a process of coagulation and sedimentation starts. It ends with four clearly distinct layers: a red region, a yellowish one, a black one, and a white one (Figure 4, left) ... The lowest part of the same column consists of sediment that is too dense to permit light to pass through. Therefore, this part of the column looks black and might be referred to as the 'black bile'. On the top of the column there is a white layer, which we today classify as fibrin; it might correspond to Galen's 'phlegm'. The remaining part is a rather clear but somewhat yellowish fluid that surrounds the coagulated column in the middle. It might be called 'yellow bile', but today we recognize it as blood serum.
- ↑ Boddice, Rob (2017). Pain: A Very Short Introduction. Oxford University Press. p. 10. ISBN 978-0-19-873856-5.
- ↑ Newton, W. (1837). "The invention of certain improvements in the manufacture of soap, which will be particularly applicable to the felting of woollen cloths". The London Journal of Arts and Sciences; and Repertory of Patent Inventions. IX: 289. Retrieved 2007-02-08.
- ↑ Martin, Geoffrey (1951). The Modern Soap and Detergent Industry: The manufacture of special soaps and detergent compositions. Technical Press. p. 15.
- ↑ "Pinapaitan - Ang Sarap". Ang Sarap (A Tagalog word for "It's Delicious"). 2013-08-13. Retrieved 2016-06-05.
- ↑ Hance, J. (2015). "Is the end of 'house of horror' bear bile factories in sight?". The Guardian.
Further reading
- Bowen, R. (2001-11-23). "Secretion of Bile and the Role of Bile Acids In Digestion". Colorado State Hypertextbook article on Bile. Archived from the original on 29 May 2007. Retrieved 2007-07-17.
- Krejčí, Z; Hanuš L.; Podstatová H.; Reifová E (1983). "A contribution to the problems of the pathogenesis and microbial etiology of cholelithiasis". Acta Universitatis Palackianae Olomucensis Facultatis Medicae. 104: 279–286. PMID 6222611.
- Maton, Anthea; Jean Hopkins; Charles William McLaughlin; Susan Johnson; Maryanna Quon Warner; David LaHart; Jill D. Wright (1993). Human Biology and Health. Englewood Cliffs, New Jersey: Prentice Hall. ISBN 0-13-981176-1.
- Seleem HM, Nada AS, Naguib MA, Abdelmaksoud OR, El-Gazzarah AR (2021). Serum immunoglobulin G4 in patients with nonmalignant common bile duct stricture. Menoufia Med J; 34:1275-83.





